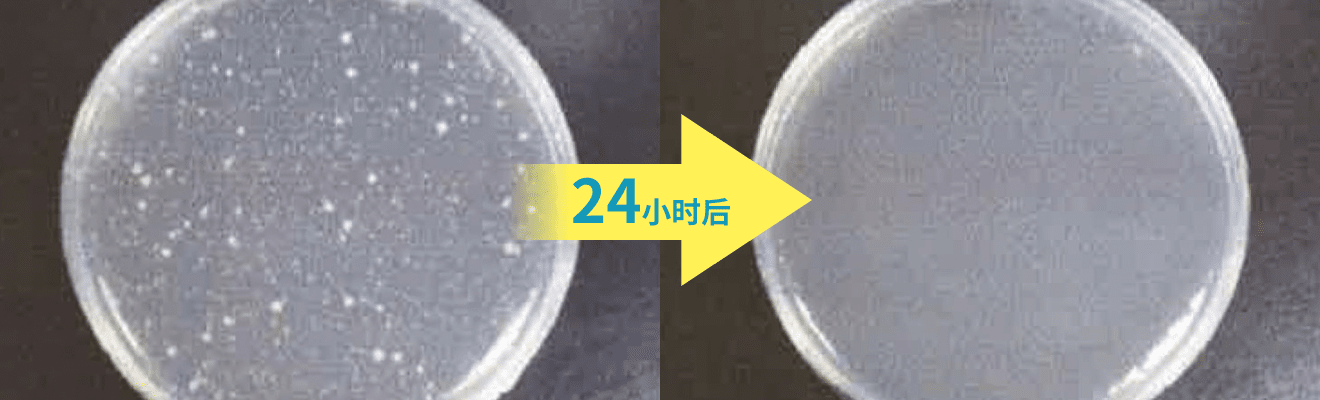

首先真心感谢广大顾客一直以来对堀内制作所产品的关心与支持,近年来,市场上出现了窃取我公司产品的实验数据报告,冠之以他名并且形状,商品名相似,效果夸大的假冒伪劣产品,这些产品质量得不到保证,存在极大安全隐患,得不到我公司的正规售后保障,严重损害了广大顾客的权益。
对于使用假冒伪劣产品产生的损害我司概不负责。此外提醒广大顾客消费者,在选购之际注意甄别品牌商品名,型号,功能效果等信息,如有疑问,请向我公司咨询。再次感谢广大顾客对我公司的厚爱与支持。

在抗菌灯的外罩表面均匀地涂了几层会产生纳米银离子的「纳米银」和能激活光催化效果的「氧化钛」,形成抗菌层。在这个抗菌层上,光与CCFL(冷阴极荧光灯管)发出的电子产生作用,发挥抗菌效果。
并且,抗菌灯的光不同于“杀菌灯”所发出的于人体有害的紫外线,在性质上与传统的荧光灯相同,能够安心地使用。














根据【病毒实验学 总论 第二修订版 丸善株式会社 病毒中和实验法】
①实验病毒溶液的处置
・往培养皿(9cm直径)倒入10毫升病毒溶液作为试验液体,培养皿内试验液深度约为3毫米。
・将实验液体放置在无尘箱内,并将其置于抗菌灯下方30厘米。
・打开培养皿盖,实验开始,分别在4个小时以及8个小时的照射以后采取样本液体进行病毒浓度测定。
・另外作为对照,采集了相同条件下未经抗菌灯照射的病毒实验液体进行测定 。(实验环境温度:25℃±2℃)
②病毒浓度测定
各个病毒液体样本进行过敏变态反应并十倍稀释后,分别注入100µL进96孔板的的细胞培养皿里,然后再加上37℃的碳酸瓦斯经过5天的培养,之后显微镜观察出现的CPE(细胞性变效应)来判断病毒是否增加以及其浓度。





ISO17025认证机构㈱食品环境卫生研究所负责实验。把流感病毒培养液用磷酸缓冲液十倍稀释使用
分别在距离实验液体30cm的抗菌灯照射实验区与非照射实验区进行0·4·8小时的静置实验,并分别测定病毒浓度。





ISO17025认证机构㈱食品环境卫生研究所负责实验。
由于诺如病毒无法培养,使用病毒培养液十倍稀释后的相似品种的猫流感病毒。
分别在距离实验液体30cm的抗菌灯照射实验区与非照射实验区进行0·4·8小时的静置,并分别测定病毒浓度。





ISO17025认证机构㈱食品环境卫生研究所负责实验。
黑曲霉,灰绿青霉,黑霉分别经马铃薯淀粉糊精培养后,用生理盐水使其孢子悬浮后取每毫升约100万个的各种霉菌,将其混合作为实验对象菌液
分别在距离实验液体30cm的抗菌灯照射实验区与非照射实验区进行0·4·8小时的静置,并分别测定其浓度。




大肠杆菌

金黄色葡萄球菌

ISO17025认证机构㈱食品环境卫生研究所负责实验。
使用空气循环器对1立方米容器里的28%氨含量的高溶度气体进行搅拌后使用。
测定经抗菌灯照射的实验区与非照射的实验区分别在0・30分钟・一个小时后的浓度。








在拥有先进烹调设备的厨房区域,安装了250个「抗菌灯」,因为有杀菌,除菌,防霉的效果,为平时的工作环境带来更安全卫生的保护。只需简单开关一下,比以前的杀菌灯更安全有效果,很是满意。



用在厨房・食堂・浴室后,更好的维持了一个干净卫生的环境,特别是在浴室等水气重的地方,防霉效果超出了期望。
在诊疗室,等待室,卫生间,处置室导入抗菌灯后的第二天,就有病人发邮件说厕所的气味很明显地没以前重了。另外没有任何噪音与费事的工程,工作人员与患者都能在干净舒适的环境中度过。



在幼儿的卫生间,小食堂,娱乐室,教室等地方导入了抗菌灯。
创造一个轻松温和的空间,对于恼人气味与各种感染症的预防起到了良好的效果,非常地不错 真的能够切身感受到祛臭,以及肉眼看不到的细菌大幅减少。

| 耗电 | 削减比 (对荧光灯) |
设计寿命 | 点灯寿命 (8h✕365日) |
电费削减额※2 (8h✕365日) |
|
|---|---|---|---|---|---|
| 一般型荧光灯 (FL40) |
43.5w | ------ | 8,000h | 2.74年 | 207元/年 |
| 单端紧凑型荧光灯 (Hf32) |
32w | 26%減 | 12,000h | 4.11年 | ▲54.75/年 |
| LED荧光灯 (標準品) |
23w | 47%減 | 40,000h | 13.7年 | ▲97.5/年 |
| CCFL抗菌荧光灯 (40w荧光灯型) |
25w | 43%減 | 40,000h | 13.7年 | ▲88.5/年 |
(※1) 上记数值为常用环境下的推测值
(※2) 简单安装一下,就能维持长效果




日本实用新案专利No.U3188344

型号:CCFL-11HV(日光白)
规格:日光白(5000k),亮度600lm PSE/EMI认证
电源:AC100-240V 功率11w 灯口E26/27
大小:直径64mm 全长129mm 重量96g
使用寿命:30000H
质量保证:购入后2年内

型号:CCFL-11HV(暖光黄)
规格:暖光黄(2700k),亮度600lm PSE/EMI认证
电源:AC100-240V 功率11w 灯口E26/27
大小:直径64mm 全长129mm 重量96g
使用寿命:30000H
质量保证:购入后2年内

型号:CCFL-BAR120WFL5
规格:日光白(5500k),亮度4200lm PSE/EMI认证
电源:AC100-240V(50/60Hz) 功率42w±10%
大小:全长1250mm 宽:230mm 高:63mm 重量2.8kg
使用寿命:40000H
质量保证:购入后2年内

型号:20D-12HV
规格:日光白(5000k),亮度700lm PSE/EMI认证
电源:AC100-240V 功率12w 灯口G13
大小:直径30mm 全长580mm 重量180g
使用寿命:40000H
质量保证:购入后2年内
※根据使用环境不同需要一定的安装工事

型号:40D-25HV
规格:日光白(5000k),亮度1600lm PSE/EMI认证
电源:AC100-240V 功率25w 灯口G13
大小:直径32(30)mm 全长1198mm 重量310g
使用寿命:40000H
质量保证:购入后2年内
※根据使用环境不同需要一定的安装工事

型号:CCFL-D12W (日光白)
规格:日光白(5000k),亮度520lm PSE/EMI认证
电源:AC100-240V 功率12w
大小:直径180(140)mm 高53mm 重量300g
使用寿命:30000H
质量保证:购入后2年内
※根据订单生产

型号:CCFL-D12Y (暖光黄)
规格:暖光黄(2700k),亮度520lm PSE/EMI认证
电源:AC100-240V 功率12w
大小:直径180(140)mm 高53mm 重量300g
使用寿命:30000H
质量保证:购入后2年内
※根据订单生产

型号:CCFL-D10W (日光白)
规格:日光白(5000k),亮度480lm PSE/EMI认证
电源:AC100-240V 功率10w
大小:直径140(100)mm 高53mm 重量220g
使用寿命:30000H
质量保证:购入后2年内
※根据订单生产

型号:CCFL-D10Y (暖光黄)
规格:暖光黄(2700k),亮度480lm PSE/EMI认证
电源:AC100-240V 功率10w
大小:直径140(100)mm 高53mm 重量220g
使用寿命:30000H
质量保证:购入后2年内
※根据订单生产

型号:S2T-UVA6W【紫外线捕虫灯】
规格:CCFL紫外线灯泡 范围效果48-70m2/台
电源:AC100 功率DC12V-6W
大小:长360mm高 200mm宽 170mm重量820g
使用寿命:15000H
质量保证:购入后2年(消耗品除外)
※根据订单生产

型号:CCFL-SLWH24
规格:日光白(6000k),亮度700lm
电源:DC24V 0.5A(Rate) 功率12w
大小:全长420mm 宽182mm 高23mm 重570g
使用寿命:30000H
质量保证:购入后2年内
※根据订单生产

型号:CCFL-SLWH24
规格:日光白(6000k),亮度700lm
电源:DC24V 1A(Rate) 功率12w
大小:全长420mm 宽182mm 高23mm 重570g
使用寿命:30000H
质量保证:购入后2年内
※根据订单生产

型号:CCFL-NSWH12
规格:日光白(6000k),亮度700lm
电源:DC24V 1.0A(Rate) 功率12w (付点烟器插头)
大小:全长360mm 宽145mm 高23mm 重550g
使用寿命:30000H
质量保证:购入后2年内
※根据订单生产
※请注意仿冒品,株式会社堀内制作所已取得CCFL抗菌灯的实用新案专利

WeChat ID:hrucsss